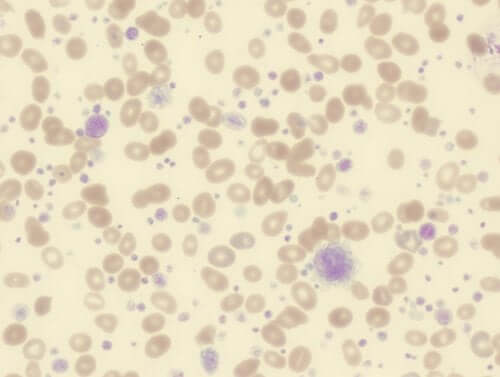
Thrombocytose : symptômes, causes et traitement

Thrombocytose : symptômes, causes et traitement
La thrombocytose est une maladie qui se caractérise par une augmentation considérable du nombre de plaquettes dans le sang. Le nombre normal de plaquettes dans le sang est compris entre 150 000 et 450 000 pour chaque microlitre de sang. Si le nombre est légèrement plus élevé ou légèrement plus bas, il est encore considéré normal. Mais si le nombre est beaucoup plus élevé, la personne souffre alors de thrombocytose
Les plaquettes sont produites dans la moelle osseuse à partir des cellules appelées mégacaryocytes. Ce sont des sortes de fragments de sang dépourvus de noyau et à la forme irrégulière. Elles jouent un rôle important dans la coagulation de sang, laquelle est nécessaire pour stopper les hémorragies.
En somme, la thrombocytose est une maladie de la moelle osseuse et du sang. Cette maladie est également connue sous le nom de thrombocytémie ou encore sous le nom de hyperplaquettose. Un nombre trop élevé de plaquettes dans l’organisme peut conduire à de graves problèmes de santé tels qu’un infarctus ou un accident cardiovasculaire, entre autres.
Les types de thrombocytose

Grosso modo, il y a deux types de thrombocytose : la thrombocytose primaire ou essentielle et la thrombocytose secondaire. Dans le cas d’une thrombocytose primaire, la moelle osseuse produit anormalement des plaquettes pour une raison que l’on ignore. Pour sa part, la thrombocytose secondaire est la conséquence d’autres maladies telles qu’une infection, un cancer, l’anémie…
Cet article peut également vous intéresser : Remèdes naturels à base d’Aloe vera pour augmenter le niveau de plaquettes naturellement
La thrombocytose peut aussi être classée en trois groupes : congénitale, acquise et pseudothrombocytose. La thrombocytose congénitale est liée au facteur héréditaire et est présente à la naissance.
Quant à la thrombocytose acquise, elle se divise en deux groupes :
- Thrombocytose primaire : la thrombocytose primaire correspond à la thrombocytose essentielle et se définit comme une néoplasie myéloproliférative causée par des mutations génétiques. Dans de nombreux cas, la cause à l’origine de la maladie est inconnue
- Thrombocytose secondaire : cette thrombocytose est la conséquence d’autres maladies. Elle concerne 85 % des cas. Plus de la moitié de ces cas sont dus a une infection
La pseudothrombocytose, pour sa part, correspond aux cas de faux positifs. Certaines circonstances font que certains fragments cytoplasmiques sont confondus avec des plaquettes, donnant alors lieu à un diagnostic erroné.
Les symptômes
Dans la plupart des cas, la maladie ne présente aucun symptôme. Elle est généralement détectée de façon accidentelle après un hémogramme. Lorsque la maladie est primaire ou essentielle, il est possible que le patient présente quelques symptômes tels que des maux de tête, des nausées, une douleur au niveau de la poitrine, une perte de vision ou la visualisation de taches.
La fatigue, les sueurs nocturnes et la perte de poids sont d’autres symptômes fréquents. La suspicion clinique est plus forte si, en plus, le patient a des antécédents d’avortements précoces au cours du premier trimestre de grossesse, de splénomégalie ou d’agrandissement de la rate, de saignements et d’hypertension.
Il est également très fréquent qu’un patient souffrant de thrombocytose essentielle présente une érythromélalgie. Il s’agit d’une vasodilatation des artères de la main et des pieds, laquelle provoque une augmentation de la température au niveau des extrémités ainsi que des démangeaisons, des douleurs et un érythème.
Cet article peut également vous intéresser : À quelle fréquence faut-il faire une analyse de sang ?
Les causes à l’origine de la thrombocytose

Tout indique que la thrombocytose essentielle est causée par une mutation somatique acquise, c’est-à-dire non héritée. Dans 50 % des cas, on constate une mutation des gênes JAK2. Dans de nombreux autres cas, on observe une mutation du gêne CARL. Il y a également eu des cas de mutations des gênes MPL, THPO et TET2.
Plusieurs de ces gênes sont chargés de fabriquer des protéines, lesquelles incident de manière décisive sur la division des cellules du sang et, en particulier, des plaquettes. On pense que la mutation provoque les symptômes de la thrombocytose essentielle, mais on ignore encore comment ce processus se déroule.
Dans de très nombreux cas, aucune mutation n’est détectée. Par conséquent, on ignore complètement quelle peut être la cause à l’origine de la forme primaire de la maladie. Quant au type secondaire, il se doit à une maladie de base comme déjà mentionné précédemment.
Le traitement
La thrombocytose essentielle ne requiert pas de traitement, à condition que l’état du patient reste stable et que ce dernier ne présente aucun signe ou symptôme de la maladie. Il se peut que le médecin recommande une prise quotidienne d’aspirine afin de prévenir la formation de caillots de sang.
Si le patient a des antécédents ou présente un risque de maladie cardiovasculaire, il est fort probable que le médecin prescrive des médicaments en vue de réduire le nombre de plaquettes. Cela est également conseillé si le patient est âgé de plus de soixante ans ou si le nombre de plaquettes est supérieur à un million.
Si la forme de la maladie est secondaire, le traitement consiste simplement à contrôler la maladie à l’origine de la thrombocytose. C’est seulement en cas d’urgence qu’il faut avoir recours à une thrombocytaphérèse ou plaqueophérèse. Ce procédé consiste en une filtration du sang similaire à une dyalise.
Toutes les sources citées ont été examinées en profondeur par notre équipe pour garantir leur qualité, leur fiabilité, leur actualité et leur validité. La bibliographie de cet article a été considérée comme fiable et précise sur le plan académique ou scientifique
- Fernández, C. M., Castillo, J. P. M., García, P. G., de Julián, E. C., & Bieler, C. B. (2008, July). Trombocitosis en la consulta de oncohematología. Descripción, diagnóstico etiológico y evolución. In Anales de Pediatría (Vol. 69, No. 1, pp. 10-14). Elsevier Doyma.
- Carrillo-Esper, R., Garnica-Escamilla, M., & Ramírez-Rosillo, F. (2013). Trombocitosis. Rev Invest Med Sur Mex.
- Badell, I., Torrent, M., & López, E. (2006). Alteraciones plaquetarias: Trombopenias y trombocitosis. Anales de Pediatria Continuada. https://doi.org/10.1016/S1696-2818(06)73584-3
Ce texte est fourni à des fins d'information uniquement et ne remplace pas la consultation d'un professionnel. En cas de doute, consultez votre spécialiste.







